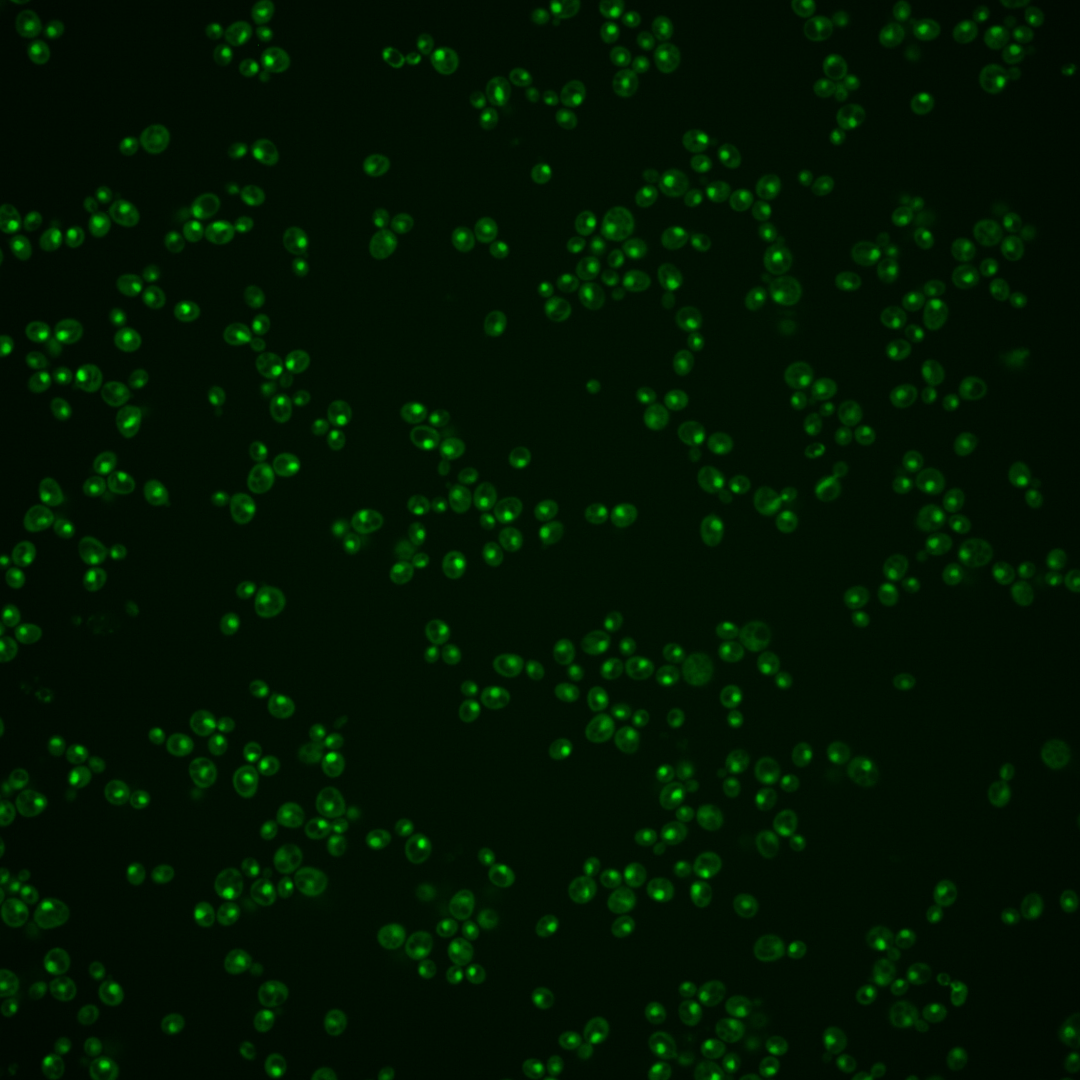
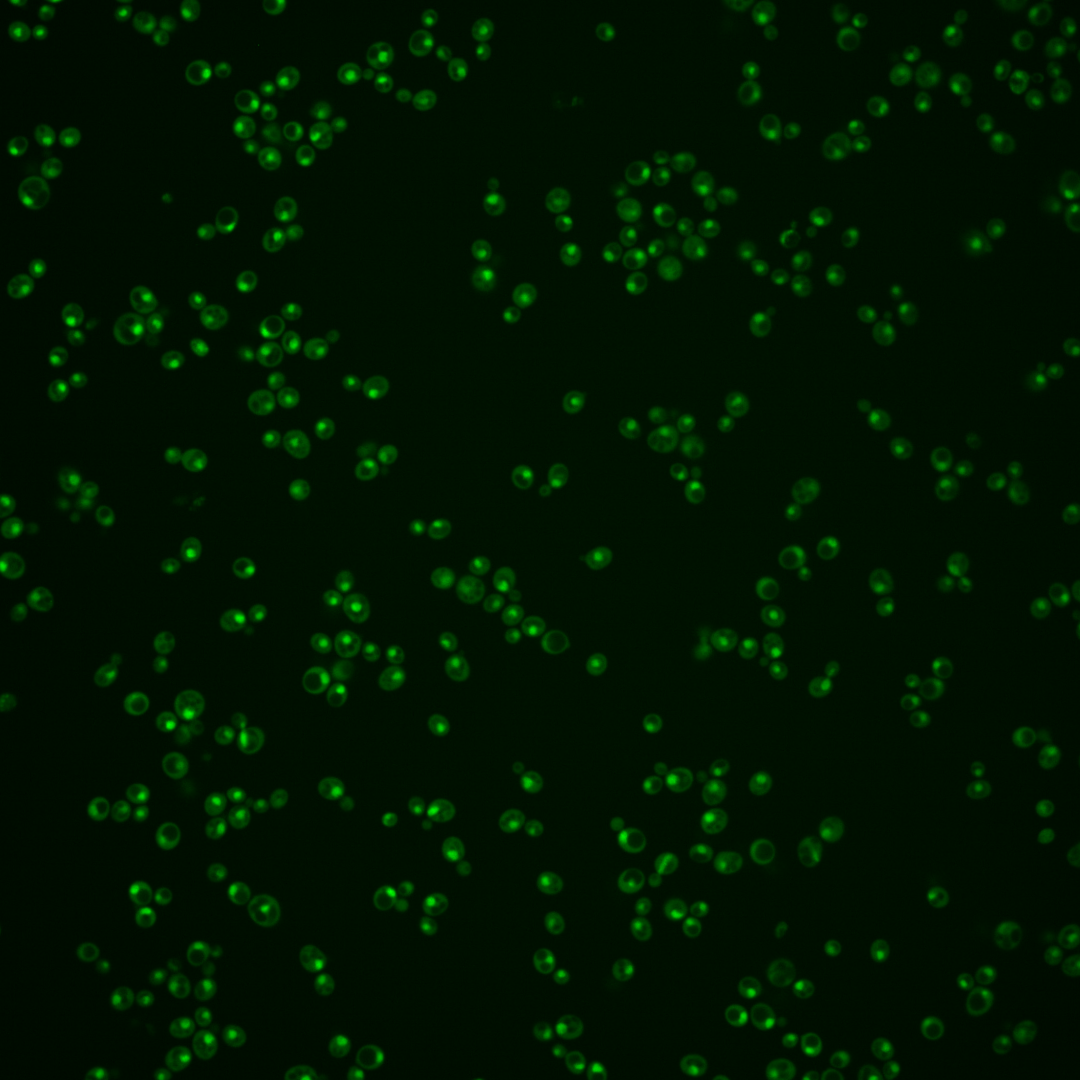

| Standard name | |
|---|---|
| Human Ortholog | |
| Description | Peptidylprolyl-cis/trans-isomerase (PPIase); specific for phosphorylated S/T residues N-terminal to proline; regulates phosphorylation of RNAPII large subunit (Rpo21p) C-terminal domain (CTD) at Ser7; associates with phospho-Ser5 form of RNAPII in vivo; present along entire coding length of genes; represses initiation of CUTs; required for efficient termination of mRNA transcription, trimethylation of histone H3; human ortholog PIN1 can complement yeast null and ts mutants |
Micrographs




















































































Sub-cellular Localization
Yeast GFP Assignment
Protein Abundance
Localization Change
External localization resources
| ensLOC | DeepLoc | |||||||||||||||||||||||
|---|---|---|---|---|---|---|---|---|---|---|---|---|---|---|---|---|---|---|---|---|---|---|---|---|
| Localization | WT1 | WT2 | WT3 | RAP60 | RAP140 | RAP220 | RAP300 | RAP380 | RAP460 | RAP540 | RAP620 | RAP700 | HU80 | HU120 | HU160 | rpd3Δ_1 | rpd3Δ_2 | rpd3Δ_3 | WT1 | WT2 | WT3 | AF100 | AF140 | AF180 |
| Cortical Patches | 0 | – | 0 | 0 | 0 | 0 | 0 | – | 0 | 1 | 0 | 2 | 0 | 0 | 0 | 1 | 0 | 0 | 0 | 0 | 0 | 0 | 0 | 0 |
| Bud | 0 | – | 0 | 0 | 0 | 2 | 1 | – | 3 | 3 | 3 | 3 | 0 | 1 | 0 | 1 | 0 | 0 | 1 | 1 | 0 | 21 | 46 | 35 |
| Bud Neck | 0 | – | 0 | 0 | 0 | 0 | 0 | – | 0 | 0 | 0 | 0 | 0 | 0 | 0 | 0 | 0 | 0 | 0 | 0 | 0 | 0 | 3 | 9 |
| Bud Site | 0 | – | 0 | 0 | 0 | 0 | 0 | – | 4 | 4 | 3 | 3 | 0 | 0 | 0 | 0 | 0 | 0 | – | – | – | – | – | – |
| Cell Periphery | 0 | – | 0 | 0 | 0 | 0 | 0 | – | 0 | 0 | 0 | 0 | 0 | 0 | 0 | 0 | 0 | 0 | 0 | 0 | 0 | 0 | 0 | 0 |
| Cytoplasm | 2 | – | 0 | 11 | 21 | 13 | 33 | – | 13 | 21 | 13 | 17 | 30 | 104 | 175 | 17 | 17 | 27 | 0 | 1 | 0 | 10 | 36 | 43 |
| Endoplasmic Reticulum | 0 | – | 0 | 0 | 0 | 0 | 0 | – | 0 | 0 | 0 | 0 | 0 | 1 | 0 | 5 | 5 | 8 | 0 | 0 | 0 | 1 | 4 | 5 |
| Endosome | 0 | – | 0 | 5 | 1 | 2 | 3 | – | 4 | 6 | 3 | 4 | 7 | 4 | 18 | 3 | 1 | 1 | 1 | 0 | 2 | 11 | 35 | 26 |
| Golgi | 0 | – | 0 | 0 | 5 | 0 | 4 | – | 0 | 1 | 0 | 0 | 10 | 18 | 17 | 6 | 10 | 19 | 0 | 0 | 0 | 0 | 1 | 3 |
| Mitochondria | 0 | – | 0 | 0 | 2 | 18 | 1 | – | 24 | 13 | 19 | 21 | 1 | 0 | 0 | 1 | 1 | 1 | 0 | 0 | 0 | 1 | 1 | 0 |
| Nucleus | 18 | – | 5 | 156 | 288 | 119 | 273 | – | 183 | 205 | 155 | 244 | 133 | 113 | 97 | 72 | 54 | 44 | 50 | 55 | 30 | 188 | 303 | 244 |
| Nuclear Periphery | 0 | – | 0 | 0 | 0 | 0 | 0 | – | 0 | 0 | 0 | 0 | 0 | 0 | 0 | 0 | 0 | 0 | 0 | 0 | 0 | 1 | 10 | 6 |
| Nucleolus | 16 | – | 8 | 0 | 7 | 19 | 9 | – | 24 | 42 | 26 | 37 | 15 | 6 | 4 | 1 | 2 | 6 | 16 | 5 | 10 | 64 | 126 | 70 |
| Peroxisomes | 0 | – | 0 | 0 | 0 | 0 | 0 | – | 0 | 0 | 0 | 0 | 0 | 0 | 0 | 0 | 0 | 0 | 0 | 0 | 0 | 0 | 0 | 0 |
| SpindlePole | 0 | – | 0 | 0 | 1 | 0 | 0 | – | 0 | 0 | 0 | 0 | 0 | 0 | 0 | 0 | 0 | 0 | 0 | 0 | 1 | 14 | 59 | 49 |
| Vac/Vac Membrane | 6 | – | 5 | 38 | 84 | 66 | 89 | – | 56 | 93 | 36 | 61 | 119 | 214 | 289 | 60 | 63 | 68 | 0 | 2 | 2 | 30 | 78 | 58 |
| Unique Cell Count | 36 | 17 | 204 | 389 | 216 | 387 | 282 | 344 | 231 | 359 | 293 | 426 | 552 | 151 | 133 | 149 | 73 | 70 | 49 | 352 | 724 | 568 | ||
| Labelled Cell Count | 42 | 18 | 210 | 409 | 239 | 413 | 311 | 389 | 258 | 392 | 315 | 461 | 600 | 167 | 153 | 174 | 73 | 70 | 49 | 352 | 724 | 568 | ||
Yeast GFP Assignment
Protein Abundance
| Screen | WT1 | WT2 | WT3 | RAP60 | RAP140 | RAP220 | RAP300 | RAP380 | RAP460 | RAP540 | RAP620 | RAP700 | HU80 | HU120 | HU160 | rpd3Δ_1 | rpd3Δ_2 | rpd3Δ_3 | AF100 | AF140 | AF180 |
|---|---|---|---|---|---|---|---|---|---|---|---|---|---|---|---|---|---|---|---|---|---|
| Mean Cell GFP Intensity (1e-4) | 10.4 | – | 8.9 | 11.8 | 12.4 | 8.0 | 11.3 | – | 9.5 | 10.2 | 9.5 | 9.9 | 14.8 | 14.7 | 14.8 | 18.2 | 19.8 | 19.5 | 12.2 | 12.4 | 12.8 |
| Std Deviation (1e-4) | 2.5 | – | 1.3 | 2.1 | 1.9 | 2.0 | 2.2 | – | 1.9 | 1.9 | 1.8 | 2.0 | 2.3 | 2.2 | 2.2 | 4.4 | 4.7 | 5.7 | 1.7 | 1.9 | 2.0 |
| Intensity Change (Log2) | – | – | – | 0.41 | 0.49 | -0.15 | 0.35 | – | 0.1 | 0.2 | 0.11 | 0.16 | 0.74 | 0.73 | 0.74 | 1.04 | 1.16 | 1.14 | 0.46 | 0.48 | 0.53 |
Localization Change
| Localization | RAP60 | RAP140 | RAP220 | RAP300 | RAP380 | RAP460 | RAP540 | RAP620 | RAP700 | HU80 | HU120 | HU160 | rpd3Δ_1 | rpd3Δ_2 | rpd3Δ_3 |
|---|---|---|---|---|---|---|---|---|---|---|---|---|---|---|---|
| Cortical Patches | 0 | 0 | 0 | 0 | – | 0 | 0 | 0 | 0 | 0 | 0 | 0 | 0 | 0 | 0 |
| Bud | 0 | 0 | 0 | 0 | – | 0 | 0 | 0 | 0 | 0 | 0 | 0 | 0 | 0 | 0 |
| Bud Neck | 0 | 0 | 0 | 0 | – | 0 | 0 | 0 | 0 | 0 | 0 | 0 | 0 | 0 | 0 |
| Bud Site | 0 | 0 | 0 | 0 | – | 0 | 0 | 0 | 0 | 0 | 0 | 0 | 0 | 0 | 0 |
| Cell Periphery | 0 | 0 | 0 | 0 | – | 0 | 0 | 0 | 0 | 0 | 0 | 0 | 0 | 0 | 0 |
| Cytoplasm | 0 | 0 | 0 | 0 | – | 0 | 0 | 0 | 0 | 0 | 0 | 2.8 | 0 | 0 | 0 |
| Endoplasmic Reticulum | 0 | 0 | 0 | 0 | – | 0 | 0 | 0 | 0 | 0 | 0 | 0 | 0 | 0 | 0 |
| Endosome | 0 | 0 | 0 | 0 | – | 0 | 0 | 0 | 0 | 0 | 0 | 0 | 0 | 0 | 0 |
| Golgi | 0 | 0 | 0 | 0 | – | 0 | 0 | 0 | 0 | 0 | 0 | 0 | 0 | 0 | 0 |
| Mitochondria | 0 | 0 | 0 | 0 | – | 0 | 0 | 0 | 0 | 0 | 0 | 0 | 0 | 0 | 0 |
| Nucleus | 4.2 | 4.0 | 2.0 | 3.6 | – | 2.9 | 2.5 | 3.1 | 3.3 | 1.3 | 0 | 0 | 1.4 | 0.9 | 0 |
| Nuclear Periphery | 0 | 0 | 0 | 0 | – | 0 | 0 | 0 | 0 | 0 | 0 | 0 | 0 | 0 | 0 |
| Nucleolus | 0 | 0 | 0 | 0 | – | 0 | 0 | 0 | 0 | 0 | 0 | 0 | 0 | 0 | 0 |
| Peroxisomes | 0 | 0 | 0 | 0 | – | 0 | 0 | 0 | 0 | 0 | 0 | 0 | 0 | 0 | 0 |
| SpindlePole | 0 | 0 | 0 | 0 | – | 0 | 0 | 0 | 0 | 0 | 0 | 0 | 0 | 0 | 0 |
| Vacuole | 0 | 0 | 0.1 | 0 | – | 0 | 0 | 0 | 0 | 0.9 | 1.7 | 1.9 | 0.8 | 1.4 | 1.3 |
External localization resources
Images






























Protein Concentration and Protein Localization Data
| R1 | R2 | R3 | ||||||||||||||||
|---|---|---|---|---|---|---|---|---|---|---|---|---|---|---|---|---|---|---|
| G1 Pre-START | G1 Post-START | S/G2 | Metaphase | Anaphase | Telophase | G1 Pre-START | G1 Post-START | S/G2 | Metaphase | Anaphase | Telophase | G1 Pre-START | G1 Post-START | S/G2 | Metaphase | Anaphase | Telophase | |
| Concentration | 7.4128 | 8.3845 | 7.9062 | 7.1942 | 7.4512 | 7.5831 | 7.8478 | 10.7195 | 8.9789 | 9.2889 | 8.6335 | 9.4461 | 9.2871 | 11.9752 | 10.0649 | 10.5739 | 9.8481 | 10.4116 |
| Actin | 0.0143 | 0 | 0.0001 | 0 | 0 | 0.0005 | 0.0222 | 0 | 0.0013 | 0 | 0.0001 | 0 | 0.0108 | 0 | 0.0046 | 0.0077 | 0 | 0.0025 |
| Bud | 0.0002 | 0.0002 | 0.0007 | 0 | 0 | 0.0001 | 0.0002 | 0 | 0.0004 | 0.0001 | 0.0001 | 0.0001 | 0.0002 | 0 | 0.0002 | 0.0002 | 0 | 0.0001 |
| Bud Neck | 0.0007 | 0.0002 | 0.0002 | 0.0001 | 0.0005 | 0.0021 | 0.0007 | 0.0001 | 0.0004 | 0.0002 | 0.0009 | 0.0024 | 0.0002 | 0.0001 | 0.0006 | 0.0003 | 0.0007 | 0.0016 |
| Bud Periphery | 0.0001 | 0 | 0.0001 | 0 | 0 | 0.0001 | 0.0003 | 0 | 0.0009 | 0 | 0.0001 | 0.0001 | 0.0002 | 0 | 0.0006 | 0.0007 | 0 | 0.0001 |
| Bud Site | 0.0003 | 0.0001 | 0.0006 | 0 | 0.0001 | 0.0001 | 0.001 | 0.0001 | 0.0055 | 0.0001 | 0.0003 | 0.0001 | 0.0004 | 0.0001 | 0.0004 | 0.0004 | 0.0001 | 0.0001 |
| Cell Periphery | 0 | 0 | 0 | 0 | 0 | 0 | 0.0001 | 0 | 0.0004 | 0 | 0 | 0 | 0.0001 | 0 | 0.0002 | 0.0002 | 0 | 0 |
| Cytoplasm | 0.0037 | 0.0024 | 0.0043 | 0.0003 | 0.0166 | 0.0017 | 0.0044 | 0.0115 | 0.0002 | 0.0004 | 0.0005 | 0.0019 | 0.0032 | 0.0058 | 0.0021 | 0.0004 | 0.0005 | 0.0003 |
| Cytoplasmic Foci | 0.0045 | 0.0004 | 0.0026 | 0 | 0.0001 | 0.0004 | 0.0055 | 0 | 0 | 0 | 0 | 0 | 0.024 | 0 | 0.0071 | 0.004 | 0.0013 | 0.0003 |
| Eisosomes | 0.0001 | 0 | 0 | 0 | 0 | 0 | 0.0004 | 0 | 0.0001 | 0 | 0 | 0 | 0.0001 | 0 | 0.0001 | 0.0002 | 0 | 0 |
| Endoplasmic Reticulum | 0.0011 | 0 | 0 | 0 | 0.0004 | 0.0004 | 0.0018 | 0 | 0.0002 | 0 | 0.0001 | 0.0001 | 0.0005 | 0 | 0.0004 | 0.0008 | 0 | 0.0002 |
| Endosome | 0.0047 | 0 | 0 | 0 | 0.0004 | 0.0008 | 0.0053 | 0 | 0.0002 | 0 | 0.0001 | 0 | 0.0049 | 0 | 0.0051 | 0.0038 | 0.0003 | 0.0018 |
| Golgi | 0.0008 | 0 | 0 | 0 | 0 | 0.0001 | 0.0022 | 0 | 0.0001 | 0 | 0 | 0 | 0.0015 | 0 | 0.0017 | 0.0022 | 0 | 0.0017 |
| Lipid Particles | 0.003 | 0 | 0 | 0 | 0 | 0.0001 | 0.0069 | 0 | 0.0001 | 0 | 0 | 0 | 0.0081 | 0 | 0.0017 | 0.0121 | 0.0003 | 0.0011 |
| Mitochondria | 0.0006 | 0.0001 | 0.0008 | 0.0001 | 0.0002 | 0.0002 | 0.0097 | 0.0001 | 0.0005 | 0.0001 | 0.0002 | 0 | 0.0046 | 0.0001 | 0.0071 | 0.0147 | 0.0001 | 0.0002 |
| None | 0.0018 | 0.0002 | 0.0018 | 0 | 0.0003 | 0.0004 | 0.0034 | 0 | 0.0001 | 0 | 0 | 0 | 0.0095 | 0 | 0.004 | 0.0003 | 0.0001 | 0 |
| Nuclear Periphery | 0.0064 | 0.0016 | 0.0017 | 0.0027 | 0.0065 | 0.005 | 0.0058 | 0.001 | 0.0009 | 0.0009 | 0.0026 | 0.0015 | 0.0041 | 0.0006 | 0.0012 | 0.0033 | 0.0014 | 0.0006 |
| Nucleolus | 0.0076 | 0.0057 | 0.0075 | 0.0021 | 0.0078 | 0.0186 | 0.0085 | 0.0046 | 0.003 | 0.003 | 0.0149 | 0.0084 | 0.0064 | 0.0062 | 0.0048 | 0.0053 | 0.0199 | 0.0092 |
| Nucleus | 0.8959 | 0.9745 | 0.9351 | 0.9943 | 0.9635 | 0.917 | 0.904 | 0.9822 | 0.9847 | 0.9949 | 0.9778 | 0.9841 | 0.8963 | 0.9859 | 0.9496 | 0.9111 | 0.9279 | 0.9794 |
| Peroxisomes | 0.0078 | 0 | 0 | 0 | 0 | 0 | 0.0085 | 0 | 0.0001 | 0 | 0 | 0 | 0.004 | 0 | 0.0048 | 0.0012 | 0 | 0.0002 |
| Punctate Nuclear | 0.0456 | 0.0145 | 0.0443 | 0.0002 | 0.0028 | 0.0519 | 0.0079 | 0.0002 | 0.0001 | 0.0003 | 0.002 | 0.0006 | 0.019 | 0.001 | 0.0016 | 0.0293 | 0.0471 | 0.0005 |
| Vacuole | 0.0006 | 0.0001 | 0.0001 | 0.0001 | 0.0006 | 0.0003 | 0.0006 | 0.0001 | 0.0007 | 0 | 0.0003 | 0.0007 | 0.0009 | 0 | 0.0016 | 0.0009 | 0.0001 | 0.0001 |
| Vacuole Periphery | 0.0002 | 0 | 0 | 0 | 0.0001 | 0.0002 | 0.0006 | 0 | 0.0001 | 0 | 0.0001 | 0.0001 | 0.0008 | 0 | 0.0004 | 0.001 | 0 | 0 |
Sequencing Data
| R1 | R2 | |||||||||
|---|---|---|---|---|---|---|---|---|---|---|
| G1 Post-START | S/G2 | Metaphase | Anaphase | Telophase | G1 Post-START | S/G2 | Metaphase | Anaphase | Telophase | |
| Gene Expression | 108.6197 | 134.5932 | 112.7149 | 99.3244 | 79.4784 | 135.4308 | 123.9365 | 122.0288 | 134.2453 | 101.5444 |
| Translational Efficiency | 1.1392 | 1.0229 | 1.1689 | 1.7788 | 1.761 | 1.1488 | 1.1523 | 1.9236 | 1.3394 | 1.363 |
Hit Data
| Dataset | Hit |
|---|---|
| Protein Concentration | ✘ |
| Protein Localization | ✘ |
| Gene Expression | ✘ |
| Translational Efficiency | ✘ |
Endocytosis
| Temp | Actin Patch (Sac6-tdTomato) | Cortical Patch (Sla1-GFP) | Late Endosome (Snf7-GFP) | Vacuole (Vph1-GFP) |
|---|---|---|---|---|
| 37℃ | ||||
| RT |
Cell Cycle Omics
CYCLoPs (Ess1-GFP)
| Gene / Allele | Actin Patch (Sac6-tdTomato) | Cortical Patch (Sla1-GFP) | Late Endosome (Snf7-GFP) | Vacuole (Sac6-tdTomato) |
|---|
| Gene | Images |
|---|
| Gene | Images |
|---|
Images are not yet available
Images are not yet available